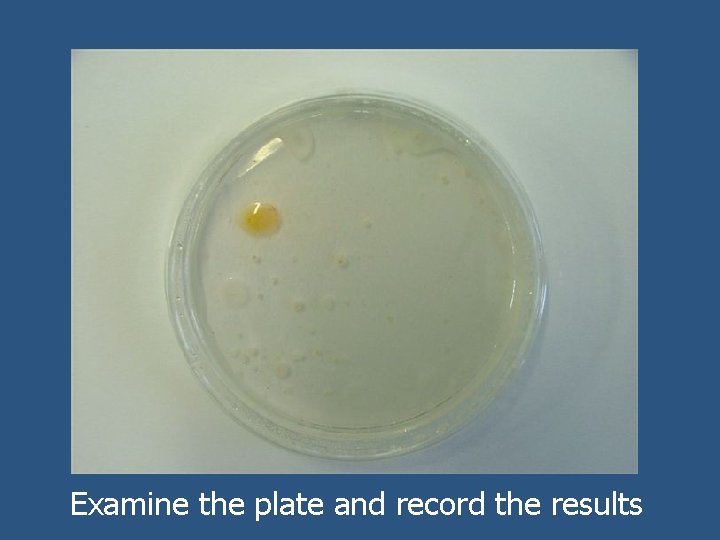
Examine the plate and record the results
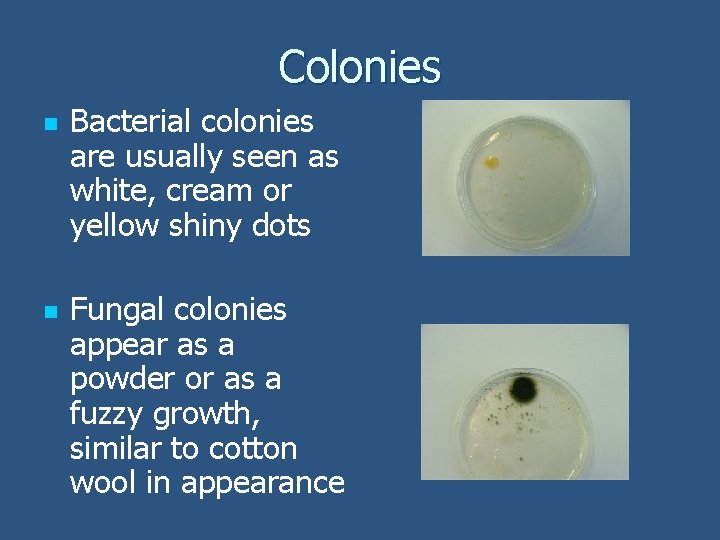
Colonies n n Bacterial colonies are usually seen as white, cream or yellow shiny

Lab procedures when handling microorganisms Distribution of microorganisms

Lab procedures when handling micro-organisms Distribution of micro-organisms in nature

Learning Objectives n n n Discuss the distribution of bacteria and fungi in nature Discuss and outline the Laboratory Procedures for Micro-organisms State precautions used when working with micro-organisms Define the terms: Asepsis & Sterility Outline containment & disposal methods in relation to microbes

Micro-organisms n n n Can only be seen with the help of a microscope Include bacteria, some fungi (yeast) and some protists (plankton) Occupy a wide range of habitats e. g. salt water, fresh water, soil, dust, air, hot springs etc. Fungi are mostly terrestrial Bacteria can be found in extreme environments from the inside of volcanoes to inside the human gut

Laboratory procedures when handling micro-organisms

Vocabulary • • Asepsis means that measures are taken to exclude unwanted organisms Sterile means that all micro-organisms are destroyed i. e. there is nothing living

Vocabulary Inoculation is the addition of cells to the nutrient medium Incubation is the growing of the microbes in a warm environment

Learning Check n n Name 3 types of Micro organisms How can you view bacteria in the laboratory? What does the term asepsis mean? What does the term sterile mean?

Growth of micro-organisms • • Under suitable conditions one microorganism can be grown into a colony of micro-organisms which is visible to the naked eye. Micro-organisms are grown on a special medium containing a food supply, most commonly nutrient agar.

Growth of micro-organisms • • The procedures involved require caution as the micro-organism to be grown (or any contaminating micro-organism, if present) may be a disease causing microbe. As a result certain precautions are taken when handling micro-organisms to reduce the possibility of contamination and to prevent the growth of undesirable microorganisms.

Precautions that can be taken when handling micro-organisms Wash hands before and after the experiment.

Precautions that can be taken when handling micro-organisms Wash the bench with disinfectant before and after the experiment.

Precautions that can be taken when handling micro-organisms Sterilise all equipment before and after use. This can be done by placing all equipment: • In an autoclave (or pressure cooker) at 120°C for 15 minutes • in Dettol for 24 hours

Precautions that can be taken when handling micro-organisms After an experiment material can be placed in a dustbin only after sterilisation Sterilised equipment can be reused

Precautions that can be taken when handling micro-organisms Flame all needles, loops and necks of test-tubes by heating them in the flame of a Bunsen burner.

Precautions that can be taken when handling micro-organisms • Turn off the Bunsen burner when not in use or make sure that the flame is visible.

Precautions that can be taken when handling micro-organisms • • Open all containers for the shortest possible time. Open lids the shortest possible distance.

Precautions that can be taken when handling micro-organisms Seal all plates once inoculated.

Precautions that can be taken when handling micro-organisms Label all plates once prepared.

Learning Check n List four precautions that should be taken when working with micro-organisms

How to grow a culture.

• n n Take a sterile agar plate. Flame an inoculating loop to sterilise it. Dip the loop into sterile water or alcohol to cool it.

n n n Flame the neck of the container from which the sample is to be taken. Inoculate the loop by placing it briefly into the sample to be grown. Re-flame the neck of the container.

While only slightly opening the agar plate streak the inoculating loop across the surface of the agar. Sterilise the loop again by flaming it.

• n Label and seal the petri-dish and incubate it upside down for 2 - 3 days. Examine the plate and record the results.

Growth n n Once the plates are sealed and labelled turn them upside down and place them in an oven (incubator) to allow any bacteria and fungi to grow. Placing them upside down reduces problems due to condensation

Yeasts and moulds grow best at 25 - 30°C. Bacteria generally require 35°C.
Examine the plate and record the results
Colonies n n Bacterial colonies are usually seen as white, cream or yellow shiny dots Fungal colonies appear as a powder or as a fuzzy growth, similar to cotton wool in appearance

Disposal All micro-organisms should be destroyed after use by sterilising all petri-dishes and equipment: n n by placing them in an autoclave (or pressure cooker) at 120°C for 15 minutes or by placing them in Dettol for 24 hours.

Learning Check n n n What growth medium is used for microorganisms? How do you inoculate a loop? How do you transfer the substance to be grown onto the agar plate? What temperature should the agar plates be incubated at? How should plates be disposed of?

Syllabus: What you need to know n n n Precautions when working with microorganisms. Asepsis and sterility: definition of each term as applied to living organisms. Containment and disposal.
- Slides: 31